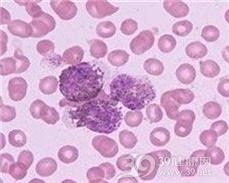

Ⅱ型免疫母细胞性淋巴腺病简介:本病临床特征与Ⅰ型免疫母细胞性淋巴腺病基本相似,但预后不良,可以看作是淋巴系肿瘤的边缘性疾病,与免疫增生不良相似。根据病理与免疫学特征,已逐渐阐明本病不同于前述的Ⅰ型免疫母细胞性淋巴腺病,也可称为T细胞淋巴瘤样免疫母细胞淋巴结病。
- 别名
- 发病部位
- 传染性
- 治愈率
- 多发人群
- 相关症状
- 并发疾病
- T细胞淋巴瘤样免疫母细胞淋巴结病
- 血液血管
- 无传染性
- 40%
- 所有人群
- 发烧,脾大,肝脾肿大
- 淋巴结炎
- 是否医保
- 挂号科室
- 治疗方法
- 治疗周期
- 治疗费用
- 临床检查
- 无
- 血液科
- 预防治疗、化学治疗
- 2-4个月
- 市三甲医院约(10000-50000元)
- 混合淋巴细胞培养试验,血凝试验
- 常见药品
- 重组人干扰素α1b注射液,重组人干扰素α1b注射液
- 在线购药
疾病症状:
一、症状
可有发热、皮疹(药物疹样)、全身淋巴结肿大,多伴有肝脾肿大。病程早期的淋巴结肿大,用抗生素或糖皮质激素治疗后常可暂时性缩小。
二、诊断
本病在病理学上多诊断为霍奇金病或纳(Lenner)淋巴瘤。但通过上述临床特征及确定肿瘤细胞和分析膜性状,可进一步确定诊断。
疾病病因:
一、发病原因
本病病因未明,有人认为本病与病毒感染有关,部分病人淋巴结中查出EB病毒的DNA(PCR法)。还有人认为由于感染了人工细胞淋巴瘤病毒的亚型,使机体免疫功能异常而导致本病。
二、发病机制
1.本病发病机制还不清楚。病人T细胞亚群分析发现本病为T细胞病变,有的病例以抑制性T细胞(TS)增多为主,有的以辅助性T细胞(TH)增多为主,亦有二者都增多。这些T细胞可能产生B细胞刺激因子,促使B细胞增殖,并分泌免疫球蛋白。Ⅱ型免疫母细胞性淋巴腺病的主要增殖细胞具有多样性,其中包括免疫母细胞和苍白细胞。前者核仁大而核幼稚,胞体呈强嗜碱性;后者胞体大而清楚,大小不等但其成熟程度相同,外观类似幼稚浆细胞,在组织学上显示为恶性增殖。
2.病理 典型的病理改变除具有Ⅰ型免疫母细胞性淋巴腺病的特征外,尚有免疫母细胞或苍白细胞肿瘤性增殖。细胞学诊断除肉芽肿性变(浆细胞增加、组织细胞和嗜酸粒细胞增加)外,尚可见有肿瘤性免疫母细胞及大而苍白的淋巴样细胞等。在病初的淋巴结,当肿瘤细胞增生少时,往往易诊断为反应性淋巴结增生。
疾病预防:
一、预防
尽一切努力避免挑起机体的免疫反应是预防自身免疫性疾病的关键。
1.消除和减少或避免发病因素,改善生活环境空间,养成良好的生活习惯,防止感染,注意饮食卫生,合理膳食调配。
2.坚持锻炼身体,增加机体抗病能力,不要过度疲劳、过度消耗,戒烟戒酒。
3.早发现早诊断早治疗,树立战胜疾病的信心,坚持治疗。保持乐观情绪。
4.预防感染,预防链球菌感染是自身免疫性风湿性疾病及并发病的重要环节。
疾病鉴别:
要与霍奇金病或纳(Lenner)淋巴瘤相鉴别。
疾病检查:
1.血液及骨髓像 可见浆细胞样异型单核细胞,但其出现率一般较低。
2.生化学检查 可见多克隆性高球蛋白血症,其升高程度与症状的恶化情况相平行。
免疫学检查:增殖的免疫母细胞及苍白细胞具有T细胞标志,且半数以上病人Ia样抗原也是阳性,无TAT活性。有些病人弓形虫抗体、麻疹病毒抗体、单纯疱疹病毒抗体等滴度非特异性升高,也有的病人可伴有Coomb阳性的溶血性贫血。
疾病就诊:
疾病治疗:
Ⅱ型免疫母细胞性淋巴腺病一般治疗
一、治疗:
此型之治疗与Ⅰ型免疫母细胞性淋巴腺病有所不同。目前多主张用化疗,但用药剂量宜小,以免引起继发感染而致死。可用小剂量糖皮质激素与小剂量长春新碱联合化疗,疗程因人而异。
在治疗过程中,若继发感染,则病原体多为革兰阴性杆菌,对此宜用足量的氨苄西林(氨苄青霉素)、庆大霉素等控制之,以延长生存期。
二、预后:
所有病人预后均不良,多在数月到两年内死亡。约20%的病例可转化为白血病,其肿瘤细胞类似异型淋巴细胞。
疾病护理:
Ⅱ型免疫母细胞性淋巴腺病一般护理
一、护理
1.消除和减少或避免发病因素,改善生活环境空间,养成良好的生活习惯,防止感染,注意饮食卫生,合理膳食调配。
2.坚持锻炼身体,增加机体抗病能力,不要过度疲劳,过度消耗,戒烟戒酒。
疾病饮食:
Ⅱ型免疫母细胞性淋巴腺病饮食原则
一、食疗方:
银花12克,芦根10克,桔梗10克,大力子9,射干9克,天葵子9克,板兰根12克,夏枯草12克,豆根9克,荆芥9克,玄参9克,花粉8克,肝草2克,荆芥9克。煎汤内服。
(上面资料仅供参考,详细需要咨询医生。)